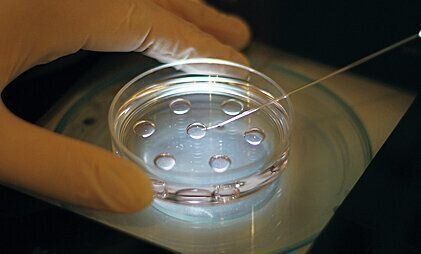
作業ごとに試験があり、合格するまで実際の作業を行うことはできない

不妊治療の考え方「テーラーメイド」という言葉を知っていますか?【専門医監修】


不妊治療を始めたら、その先に検討すべきか迷うのが「体外受精」。
そもそも体外受精といってもいろいろな方法があるようで、特徴的なクリニックを訪問し初心者ならではの質問をぶつけました。
今回は、不妊治療の考え方のひとつ「テーラーメイド」について、医療法人オーク会医師 田口早桐先生にご回答いただきました。
3つのタイプのクリニックに素朴な疑問を聞いてみた!Q&A #3
※参考:「妊活たまごクラブ 不妊治療クリニック受診ガイド 2021-2022」
【Q1】不妊治療で「テーラーメイド」という言葉を耳にしました
【A1】根本的な原因を探りながら、一人ひとりに合った生殖医療を提供するのがテーラーメイドです
●田口早桐先生(以下、田口先生) 「妊娠を望みながら、なかなか叶わない人にはそれぞれの原因や事情があります。その根本を探りながら、排卵誘発や採卵の方法、移植のスケジュールなど、一人ひとりに合った柔軟な生殖医療を提供するのが「テーラーメイド」の不妊治療です。妊娠しやすい体質づくりから高度な生殖医療技術まで、体外受精や顕微授精はもちろんですが、ダイエット指導や、そもそも性交が難しい場合へのシリンジ法(器具で膣に精液を自分たちで注入する方法)まで幅広く対応します」
選べる治療法例
□ タイミング法
尿中のLH濃度や超音波検査などで、できる限り正確な排卵日を予測して、妊娠しやすいタイミングが持てるように調べます。また、自然周期によるタイミング指導に加え、必要に応じて排卵誘発剤を使用するケースも
□ 人工授精
男性のマスターベーションで採取した精液を培養液で洗浄濃縮して、女性が妊娠しやすい時期に子宮内に注入する方法。「人工授精」といっても、注入された精子と卵子が受精するのは卵管なので、自然妊娠と同じ原理です
□ 体外受精
タイミング法を3回程度行っても妊娠が成立しない場合、人工授精、そして体外受精へと移行します。ステップアップして、途中で「自然妊娠するかも…」と思われたら、体外受精からまたタイミング法に戻ってもOKです
□ 顕微授精
顕微鏡で拡大しながら、精子を卵子に直接注入して受精を促す方法。数多くの精子の中から一つを選別して細いガラス針に取り込み、これを卵子に注入します。英語の頭文字をとって「ICSI(イクシイ)」とも呼ばれています
【Q2】不妊治療を考え始めたばかりで、何が自分に合っているのかよくわからないのですが…
【A2】電話やメール、オンラインなどで、不安に思っていることを相談しましょう
●田口先生 「不妊治療は専門用語も多いですし、初めてのことでわからないことや不安、悩みを抱えているかはたくさんいらっしゃいます。まずはどうしたいのか、率直な思いを電話やメールなどで伝えるといいでしょう。不妊治療に関する知識がゼロというかたには、オンライン動画も用意しています。最低限の知識を身につけた上で、ご希望を交えて相談すると、その後治療に進んだときにコミュニケーションがスムーズです。生殖医療の経験豊富なスタッフへの相談は無料で、治療方針や料金など細かいことでもOK」
不妊治療の基礎知識から高度治療までわかる動画を多数用意
【Q3】不妊治療を考えていても仕事が忙しくてなかなかスタートできません!
【A3】初診でもオンライン診療が可能。問診票などの書類もネット上に用意
●田口先生 「当院では以前からオンラインでの診療に力を入れていますが、コロナ禍の対策の一つとして全国的にもオンライン診療が増えています。問診票などの書類はPDFにしてダウンロードできますし、クリニックの説明動画も多数用意し、妊娠検査薬の使い方や自己注射の方法も知ることができます。仕事が忙しい人はもちろん、全国どこに住んでいても、自宅からカップルで受診することができるのもオンラインのメリットです」
【Q4】太っていると妊娠しにくく、出産も危険が伴うって本当ですか?
【A4】本当です! 妊活中の時期に適正体重に戻しましょう
●田口先生 「最近の研究では肥満によって脂肪細胞内のアディポネクチンが減ると、卵巣の皮がぶ厚くなり、卵子がうまく育たなかったり、排卵しにくくなることがわかっています。妊娠しても、産道に脂肪がついたままでは難産になりやすく、帝王切開したとしても脂肪が厚いと傷が治りにくい上、血栓症などの合併症を起こしやすくなります。当院では医学的なプログラム「オーク式ダイエット」を開発。体を大切にしながら確実に効果を上げることができるよう、徹底的にサポートします」
【Q5】私が妊娠しにくい理由はもしかして夫に原因があるかもと疑ったときはどうしたらいい?
【A5】男性不妊外来も設けているのでまずは受診から始めてみては
●田口先生 「一般的に精子は2億個(1mlあたり5000万〜1億個)くらいいますが、受精の場である卵管膨大部にたどり着くころには100個ぐらいになり、最終的には1個の精子が卵子と出合って受精します。その過程のどれか一つにでも異常があると、受精は成立しません。当院では女性だけでなく、男性不妊外来も設けており、精巣から直接精子を採取する「TESE」にも対応しています」
【培養室をCheck!】オーク銀座レディースクリニック
どんなオーダーにも対応できるよう研修や実技試験を重ねた精鋭スタッフが対応
失敗の許されない作業を日々こなすスタッフ
安心して治療が受けられる管理システム
高度な技術と知識が要求される作業
凍結後の管理も重要な業務
■監修
●撮影/合田和弘
●イラスト/コナガイ香
●構成・文/飯田由美(BEAM)
※記事内容、日付、監修者の肩書、年齢などは掲載当時のものです。


 SHOP
SHOP 内祝い
内祝い